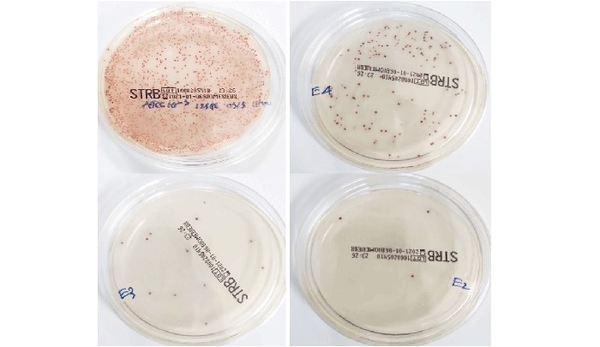

Quy trình real-time PCR phát hiện liên cầu khuẩn nhóm B (GBS) ở thai phụ, do nhóm tác giả Bệnh viện Đại học Y Dược TPHCM xây dựng, cho thời gianh nhanh, chính xác với chi phí hợp lý.


Thí nghiệm xác định lạc khuẩn GBS
Liên cầu khuẩn nhóm B (GBS) là các trực khuẩn Gram dương hiếu khí, gây viêm họng, viêm phổi, nhiễm trùng vết thương da và nhiễm trùng huyết. Đây là tác nhân gây nhiễm khuẩn hàng đầu và là nguyên nhân chính gây ra bệnh tật, tử vong ở trẻ sơ sinh. Nhiễm GBS giai đoạn sớm gây viêm phổi, nhiễm trùng huyết và viêm màng não. Sự lây truyền từ mẹ sang con có thể xảy ra khi thai phụ có nhiễm GBS ở âm đạo, trực tràng vào thời điểm chuyển dạ hoặc vỡ ối, là yếu tố nguy cơ cao và quan trọng đối với nhiễm trùng sơ sinh sớm.
Tại Việt Nam, một số bệnh viện phụ sản lớn đã áp dụng tầm soát GBS cho các phụ nữ mang thai tuần thứ 35-37 và sử dụng phác đồ điều trị theo hướng dẫn của Trung tâm kiểm soát và phòng ngừa dịch bệnh Hoa Kỳ (CDC). Việc chẩn đoán, sàng lọc GBS ở thai phụ chủ yếu được thực hiện theo kỹ thuật nuôi cấy, cho kết quá sau 4 – 5 ngày. Chỉ một số ít bệnh viện thực hiện xét nghiệm sàng lọc GBS bằng kỹ thuật real-time PCR, cho kết quả trong 48 giờ. Tuy nhiên, đây vẫn là khoảng thời gian dài, nên cần có một quy trình sàng lọc cho kết quả nhanh hơn (khoảng 2 giờ), để em bé sinh ra được an toàn, tránh các trường hợp bị nhiễm trùng sơ sinh sớm. Để khắc phục hạn chế này, nhóm nghiên cứu tại Bệnh viện Đại học Y Dược TP. Hồ Chí Minh đã xây dựng Quy trình real-time PCR phát hiện liên cầu khuẩn nhóm B ở thai phụ.
Tại Cơ sở 2, Bệnh viện Đại học Y Dược TP. Hồ Chí Minh, 259 thai phụ đủ tháng (tuổi thai trên 37 tuần) được phết lẫy mẫu ở âm đạo - trực tràng, để xác định các giá trị chẩn đoán lâm sàng của quy trình real-time PCR tối ưu trong nghiên cứu. Để đánh giá giá trị chẩn đoán của quy trình real-time PCR, các tác giả đã sử dụng phương pháp nuôi cấy với môi trường sinh màu. Theo đó, khuẩn lạc GBS có hình thái xác định là màu hồng, bờ đều, mặt lồi đều bóng. Ngoài ra, nhóm nghiên cứu còn thiết kế lại chương trình nhiệt (để phá hủy màng tế bào) của phản ứng real-time PCR 9 và lựa chọn hệ enzyme phù hợp.
Kết quả là quy trình real-time PCR cải tiến giúp phát hiện GBS nhanh với độ chính xác đạt 96,83%, độ nhạy 93, 94% và độ đặc hiệu 97,93%. Kết quả này tương đương với các kit thương mại Sacace. Thời gian thực hiện quy trình mất khoảng 87 phút/mẫu xét nghiệm (nhanh hơn sử dụng kit thương mại 47 phút).
Về chi phí hóa chất cho một xét nghiệm real-time PCR phát hiện GBS bằng kit thương mại là 230.000 đồng/test, chưa kể chi phí hóa chất tách chiết. Trong khi đó, chi phí hóa chất cho một xét nghiệm GBS trong nghiên cứu này rơi vào khoảng 150.000 – 180.000 đồng/test. Do đó, kết quả đề tài có thể áp dụng vào thực hành lâm sàng để phục vụ cho người dân với tiêu chí nhanh, chính xác với chi phí phù hợp, đáp ứng được nhu cầu sàng lọc GBS cho thai phụ.
Nguồn: N.P.D (tổng hợp)